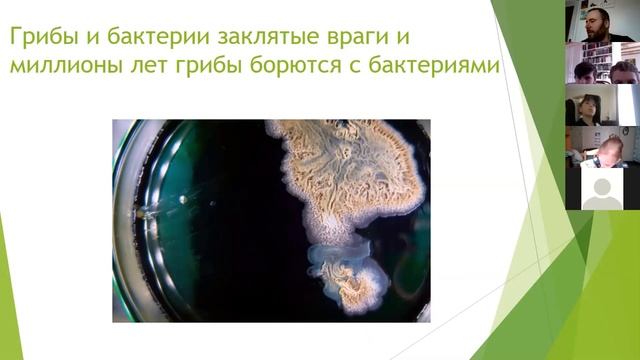
Онлайн занятие Маленький принц Увлекательные науки Грибы 8 смотреть онлайн

Автор / Канал: Тайное понимание путей образования эзотерической магии Страница 4

Нож «Ловец снов XXL». Сталь n690.

Рецепт пирога.Простой и очень вкусный рецепт пирога пошагово.Идеи для бюджетного ужина.Дешевый ужин

Конференция по ЭКОТЕОЛОГИИ в г.Владимир 21-10-2022

Вебинар "Анатомия любви"

Бизнес разборка. Выпуск 14. Психология и бизнес.

Покупки для новорожденного. Часть 2. Лучшие подгузники, игрушки, выбор стульчика для кормления.

OSU! gameplay sgeg playing Niki, Wave (Insane)

ракета с Плесецка

Прямой эфир по грамматике турецкого языка "Aile - Семья"

Разрушение - ремонт - разрушение...

СТРАШНЫЕ ИСТОРИИ - Плохая ночь (Морг)
![Akmal' — Приснись [Speed Up] смотреть онлайн Akmal' — Приснись [Speed Up] смотреть онлайн](https://pic.rtbcdn.ru/video/ab/4e/ab4ec434d16f41eae50769b4a4f266f3.jpg)
Akmal' — Приснись [Speed Up]
Онлайн занятие Маленький принц Увлекательные науки Грибы 8

07.04.2018 14:00 Мода

Мои дела перед сном??

Осенние листья. Юрий Богданов. feuilles de l'automne.

Подрезали на МКАД. Разложился на заправке))) Еду за рулем Rizoma. Гонки. Пробки МКАД прекрасны?

【死ぬまでに行きたいキャンプ場】これ見る為に仕事頑張った…

Рохан Виджей о миофункциональном подходе к лечению прикуса

Со Кан Джун & Гон Сын Ён - crossover

Если не знаешь что такое мгновение, ты мёртв. Василий Керечанин.Он-лайн сатсанг 30.07.22.

Вторая экскурсия Приморского Сафари-парка
![ЖУКИ [2 сезон 17 серия] - Лучшие Сериалы и Фильмы, топовые рекомендации, когда будет продолжение? смотреть онлайн ЖУКИ [2 сезон 17 серия] - Лучшие Сериалы и Фильмы, топовые рекомендации, когда будет продолжение? смотреть онлайн](https://pic.rtbcdn.ru/video/c1/81/c181a3ea477b5addf68f1491a4bba165.jpg)
ЖУКИ [2 сезон 17 серия] - Лучшие Сериалы и Фильмы, топовые рекомендации, когда будет продолжение?

Форсаж Продаж грузовых авто по Украине Купить грузовую машину недорого черкассы
За каждым успешным каналом стоит личность, идея и сотни часов кропотливого труда. Если вы здесь, значит, автор «Тайное понимание путей образования эзотерической магии» уже сумел зацепить ваше внимание своим уникальным стилем или подачей. А мы на RUVIDEO позаботились о том, чтобы вы могли изучить весь архив его работ в максимально комфортных условиях — без лишней суеты и преград.
Почему за работами канала «Тайное понимание путей образования эзотерической магии» так интересно наблюдать? Всё просто: это честный контент, который находит отклик в сердцах зрителей. На нашем ресурсе вы можете смотреть онлайн все видео любимого автора бесплатно и в хорошем качестве. Нам важно, чтобы вы видели каждую деталь и слышали каждый нюанс, поэтому мы используем только стабильные плееры из открытых источников Rutube.
Следите за новинками канала, пересматривайте старые шедевры и открывайте для себя новые грани творчества «Тайное понимание путей образования эзотерической магии». Мы постоянно обновляем ленту, чтобы у вас под рукой всегда были самые свежие выпуски. Никаких сложных регистраций — только вы и творчество, которое вдохновляет. Приятного вам путешествия по миру авторского контента на RUVIDEO!
Видео взято из открытых источников Rutube. Если вы правообладатель, обратитесь к первоисточнику.